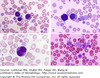

Heme Malignancies I Flashcards
t(11:14)
Mantle cell lymphoma (Non-Hodgkin’s Lymphoma)
Which leukemia highly associated with DIC?
APL
“Core binding factor” leukemia and it’s associated cytogenetics
Acute myelomonocytic leukemia - inv(16:16)
Gingival hyperplasia
AML
Heart-shaped/bat wing nuclei?
APL
Arsenic MOA?
Breaks down PML-RARalpha fusion protein
BBW for Arsenic?
CV - QT prolongation, AV block, etc
CD14+/CD11b+
Acute myelomonocytic leukemia
Definition of class I hypothesis
Fusion gene causes constitutively active pro-proliferation gene
Definition of class II hypothesis
Fusion gene acts as a corepressor, inhibiting differentiation
AML translocations fit under class ___ hypothesis
II (inhibits differentiation of myelocytes)
AML associated with eosinophilia?
Acute myelomonocytic leukemia
Epidemiology of hairy cell leukemia?
Middle aged (~40yo) male
Most common cutaneous lymphoma and its cell?
Mycoses fungoides - Sezary cell
Which AML does NOT have CD34+ immunophenotype?
APL
Which method used to asses immunophenotype?
Flow cytometry
First step in workup of any heme disease
PBS
Five criteria to classify something as a blast
- Big cell 2. Increased cytoplasm:nuclear ratio 3. Immature chromatin 4. Large nucleus (may be >1 nucleus) 5. Bunch of cells that look alike
3 steps in bone marrow aspiration
- Half cc of bloody aspirate 2. 5-20 cc in same spot for special studies 3. Core biopsy from different site
Purpose of core biopsy in new spot
Will not contain blood if you draw from same site where aspirate was done
Normal range of myeloid:erythroid precurors
2:1 - 5:1 (myeloid should always outnumber erythroid precursors)
How to estimate cellularity of bone marrow
100-age (rest is fat)
Hapten
Site where an antigen binds (so a CD is a hapten)
Flow is a weak method for detecting ____ cells. Why?
Erythroid precursors - they’re lysed before flow so they’re underrepresented on scatter plots